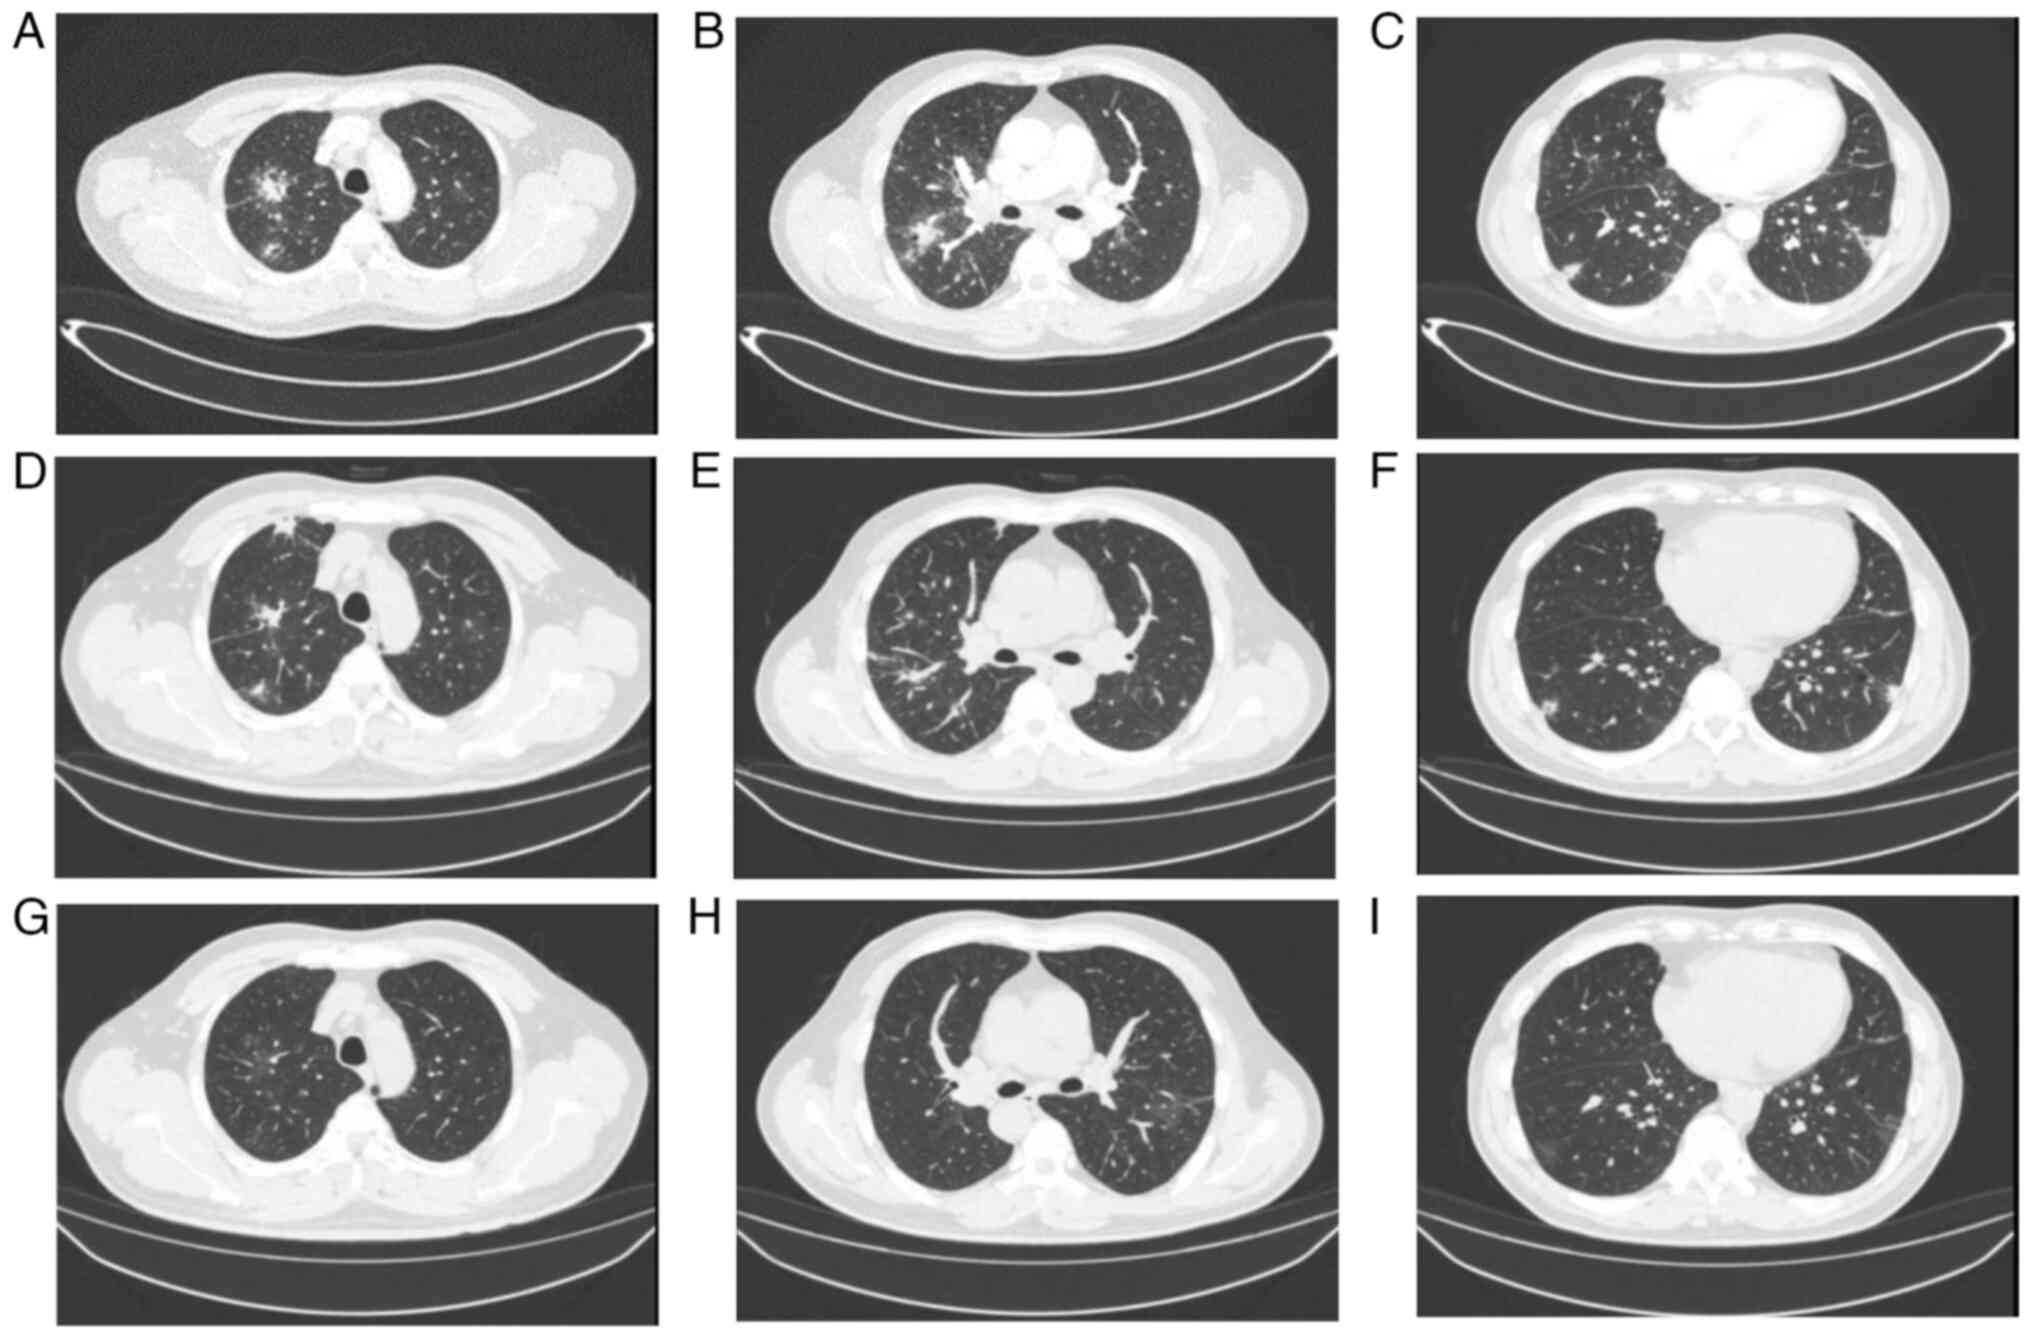

Introduction
Whipple's disease (WD) is a complicated and rarely
chronic multi-system disease caused by Tropheryma whipplei
(T. whipplei); while the disease has been observed and
investigated for >100 years, it remains a difficult diagnostic
and therapeutic challenge in clinical practice (1,2). The
majority of cases of WD disease have been reported in North America
and Europe, with only a minority of cases reported in native Asian
and African individuals (3). The
annual incidence rate is an approximate of <1,000,000, with a
mean age of onset of symptoms of 55 years (3,4). The
disease is more frequent in the male population, with a male/female
ratio of 4:1(5).
The imaging manifestations of WD lung involvement
are also diverse, with the most common chest imaging manifestations
being nodules, interstitial changes and patchy infiltrates, of
which nodules are the most commonly observed, with cavitation-like
changes, pleural thickening and pleural effusion being less common
(6). WD is mainly a chronic
infection with multi-organ involvement, with occasional acute onset
(7). Due to the heterogeneity of
the clinical manifestations of the disease and the variety of
imaging manifestations, there is a possibility that the disease may
not be diagnosed and treated in a timely manner, leading to serious
consequences or even mortalities (7).
The present article presents an analysis of three
patients with WD admitted to the Department of Respiratory
Medicine, The Second Affiliated Hospital of Chongqing Medical
University (Chongqing, China) from January 2022 to August 2023, as
well as a review of the relevant literature, with the goal of
raising awareness of WD for clinical physicians.
The Clinical characteristics of three patients with
WD are presented in Table I. All
patients had signed the informed consent form and consented to
publication appropriately.
 | Table IClinical characteristics of patients
with Whipple's disease. |
Table I
Clinical characteristics of patients
with Whipple's disease.
| Patient no. | Sex | Age, years | Past medical
history | Fever | Cough, sputum, joint
pain, abdominal pain, diarrhea and weight loss? | Chest pain | Other | BMI,
kg/m2 |
|---|
| 1 | Male | 53 | Pulmonary nodule | No | Yes | Yes | Headaches | 28.1 |
| 2 | Male | 37 | Bronchial asthma | Yes | Yes | No | Dyspnea | 26.0 |
| 3 | Female | 34 | Thyroid cysts,
adenomyosis, post-chocolate cyst debridement | No | Yes | Yes | Headaches | 28.8 |
Case report
Case 1
A 53-year-old male presented to the Second
Affiliated Hospital of Chongqing Medical University (Chongqing,
China) outpatient clinic with persistent chest pain on the right
side that was aggravated by inspiration, accompanied by dizziness,
headache, cough, and white mucous sputum, with progressive
aggravation of the symptoms. The patient was admitted to our
outpatient clinic with the condition of ‘Chest pain to be
investigated’ (July 2023). Since the onset of the disease, the
mental health and appetite of the patient were fine, his bowel and
urine were normal and there was no significant change in his
weight. Past history was physically healthy. A physical examination
of the heart, lungs and abdomen revealed no abnormalities. On the
same day as presentation, a computed tomography (CT)-enhanced
examination of the chest revealed (Fig. 1A-C): i) Possible infectious lesions
in both lungs; ii) multiple enlarged lymph nodes in the hilar and
mediastinum of both lungs; iii) multiple air-containing cystic
cavities in both lungs; iv) minor effusions in the pleural cavities
bilaterally; and v) sclerosis of the aorta and coronary
arteries.
At 2-days post admission, brain MRI revealed: i)
High signal in the cerebral white matter (Fazekas grade I)
considered to be associated with small vessel hemorrhage; and ii)
no other structural or organizational abnormalities. Electron
bronchoscopy revealed that the left and right main bronchi and
their mucous membranes of the lobes and segments were congested,
carbon deposition was observed in the middle lobe of the right lung
and a white, thin sputum was observed. The results of other
relevant laboratory tests are presented in Table II.
 | Table IILaboratory Results in patients with
Whipple's Disease. |
Table II
Laboratory Results in patients with
Whipple's Disease.
| Inspection and
examination | Case 1 | Case 2 | Case 3 |
|---|
| Hemoglobin (115-150
g/l) | 130 | 137 | 140 |
| WBC (3.5-9.5
g/l) | 5.16 | 14.24 | 5.53 |
| N, % (45-75%) | 68 | 93.8 | 59.5 |
| L, % (20-50%) | 15.3 | 2.2 | 31.1 |
| Ultra-sensitive CRP
<1 mg/l | >5 | >5 | 1.82 |
| CRP (<10
mg/l) | 75.31 | 52.44 | <5 |
| PCT (0.02-0.05
ng/ml) | 0.15 | 0.3 | 0.03 |
| Fecal occult
blood | (-) | (-) | (±) |
| Creatine kinase
(38-174 U/l) | 119.5 | 581 | 187 |
| ESR (0-15 mm/first
h) | 79 | - | - |
| GGT (10-60 U/l) | 103 | 79 | 19 |
| ALT (9-50 U/l) | 39 | 52 | 16 |
| AST (15-40 U/l) | 37 | 29 | 20 |
| Serum albumin | 41.8 | 41.4 | 39.3 |
| Respiratory
failure | No | Yes | No |
| Chest CT | (July 2023) Multiple
patches, nodules and striated high-density shadows in both lungs
with uneven density and unclear borders, with thickening of the
surrounding interlobular septa, and some foci located in the
bilateral subpleura in the adjacent pleura with slightly thickened
adhesions | (March 2023)
Scattered inflammation and nodules in the upper lobes of both lungs
and the lower lobe of the right lung | (January 2022)
Patchy solid metaplasia and perifocal small speckled exudates in
the extra-basal segment of the lower lobe of the right lung,
considering the possibility of an infectious lesion |
| Alveolar lavage
fluid mNGS results | 219 for T.
whipplei, 1 for Pneumocystis japonicus | 21,793 for T .
whipplei, and 20,889 for the influenza A virus | T.
whipplei |
Therefore, the patient was initially diagnosed with
pneumonia and WD. Meropenem 1 g* q8h anti-infective treatment was
given, and the patient was discharged after 8 days of symptom
improvement, followed by cotrimoxazole 0.96 g bis in die
(BID; twice a day) maintenance treatment for 1 year.
After treatment, the chest CT was reviewed in July
2023 (Fig. 1D-F) and August 2023
(Fig. 1G-I), respectively, and
significant improvement of the lesion was observed.
Case 2
A 37-year-old male was admitted to the Second
Affiliated Hospital of Chongqing Medical University (Chongqing,
China) in March 2023, with recurrent wheezing for 4 months,
aggravated by fever for 3 days. The patient was intubated, sedated,
and administered an analgesic, so the examinations were limited,
and the findings of the relevant physical examinations were as
follows: Respiratory sounds were low bilaterally, and no obvious
rales or wet rhonchi were heard. A physical examination of the
heart and abdomen revealed no abnormalities. Electronic
bronchoscopy was performed and bronchial congestion and edema were
observed in all lobe segments of the left lung and the upper and
lower lobes of the right lung; a small amount of yellowish-white
mucous sputum was aspirated.
At 6 days post-admission, a chest CT (Fig. 2A-C) suggested scattered
inflammation and nodules in the upper lobes of both lungs and the
lower lobe of the right lung. The results of metagenomic
second-generation sequencing (mNGS) and other relevant laboratory
tests are presented in Table II.
The initial diagnosis was critical bronchial asthma, type II
respiratory failure, WD and influenza A.
Invasive ventilation, anti-inflammatory
[methylprednisolone 40 mg quaque die (qd) for 5 days], and
bronchodilator (budesonide 2 mg BID for 7 days) treatments were
given, followed by oseltamivir antiviral and ceftriaxone 2 g qd
anti-infective treatments for 7 days. According to the mNGS
results, symptoms of wheezing, exhaustion and dyspnea improved.
influenza A nucleic acid was negative, and the patient was
discharged, with postminocycline 200 mg quaque 12 hora
(every 12 h), and 100 mg BID for maintenance treatment for 1
year.
Subsequent review of the chest CT in April 2023
(Fig. 2D-F) and August 2023
(Fig. 2G-I) showed significant
improvement of the lesion.
Case 3
A 34-year-old female patient was admitted to the
Second Affiliated Hospital of Chongqing Medical University
(Chongqing, China) in January 2022, with a cough that had been
worsening for >1 month and had been present for half a month.
Chest CT in January 2022 (Fig.
3A-C) revealed: i) Patchy solid shadow and small perifocal
speckled exudative foci in the extra-basal segment of the lower
lobe of the right lung, indicating the possibility of an infectious
lesion; and ii) several small nodular foci in both lungs. An
electronic bronchoscopy was performed, which revealed congested and
swollen bronchial tubes in all lobar segments bilaterally. The
results of mNGS and other relevant laboratory tests are presented
in Table II.
Therefore, the initial diagnosis was pneumonia with
WD. The patient was discharged from the hospital after 7 days of
anti-infective treatment with ceftriaxone (2 g qd), followed by
maintenance treatment with cotrimoxazole (0.96 g BID).
Subsequently, a follow-up chest CT in January 2023 (Fig. 3D-F) and March 2023 (Fig. 3G-I) showed significant improvement
of the lesion.
Discussion
The present study diagnosed two male and one female
patients; all three were middle-aged patients with an average age
of 41.3 years. In terms of clinical symptoms, all three patients
had cough and sputum; two had chest pain; two had mixed headache
manifestations; and one had fever and dyspnea that were thought to
be associated with influenza A and bronchial asthma. One of the
three patients had elevated leukocyte and neutrophil percentages,
two had decreased lymphocyte percentages, all three patients had
ultrasensitive C-reaction protein (CRP) and significantly elevated
CRP, two patients had increased calcitoninogen, two patients had
raised creatine kinase and γ-glutamyl transpeptadase, and one
patient with influenza A and bronchial asthma had combined
respiratory failure and was critically ill. The chest CT
manifestations of the three patients showed exudative changes in
the form of patches of shadows; two patients showed lung nodules,
and one patient had pleural thickenings and adhesion
manifestations.
In terms of treatment protocols, one patient was
given meropenem as the starting regimen and two were given
ceftriaxone as the starting regimen; furthermore, two were provided
with a maintenance regimen of cotrimoxazole and one was given a
maintenance regimen of minocycline; the mean hospitalization day of
the three patients was 12.3 days, and the mean hospitalization cost
was $3,900 (Table III). After
the treatment, all three patients improved, and the lesions were
significantly improved.
 | Table IIITreatment and cost of patients with
Whipple's Disease. |
Table III
Treatment and cost of patients with
Whipple's Disease.
| Clinical data | Case 1 | Case 2 | Cases 3 |
|---|
| Therapeutic
regimen | Meropenem 1 g q8h*8
days | Ceftriaxone 2 g
qd*7 days | Ceftriaxone 2 g
qd*7 days |
| Maintenance
regimen | Cotrimoxazole 0.92
g BID | Minocycline 100 mg
BID | Cotrimoxazole 0.92
g BID |
| Average
hospitalization days | 16 | 12 | 10 |
| Hospitalization
costs ($) | 3,080 | 5,460 | 1,820 |
T. whipplei is a gram-positive bacterium
found mainly in water and soil. WD is most commonly seen in
immunodeficient patients, such as HIV-infected patients with low
CD4 levels, use of corticosteroid hormone therapy, diabetes
mellitus, tumors, organ transplants and the use of TNF-α
inhibitors, who are usually infected after contact with
contaminated soil or water (8,9). WD
is genetically susceptible to the human leukocyte antigen alleles
DRB1*13 and DQB1*06(10). WD
mainly affects the digestive tract, nervous system, heart and skin,
and less frequently the lungs. It has been reported that the
respiratory infection rate of WD is only 13-14%, that the digestive
system mainly manifests symptoms such as weight loss due to
malabsorption, abdominal pain and diarrhea, and that some patients
suffer from insidious gastrointestinal hemorrhage; some patients
also have hidden gastrointestinal bleeding (10,11).
The common clinical manifestations of the respiratory system are
chest pain, dyspnea, chronic cough and phlegm (8). Other systems are characterized by
migratory arthritis, uveitis, endocarditis, pericarditis and a
variety of neurological symptoms (12).
Laboratory results of WD showed that 90% of patients
have combined anemia as well as iron, folate or vitamin B12
deficiencies, and ~1/3 had neutrophilia with decreased lymphocyte
counts, hypoalbuminemia and elevated C-reactive protein being more
common; if T. whipplei nucleic acid is not detected before
treatment, some patients may test negative for T. whipplei
nucleic acid after broad-spectrum antibiotic therapy, but this may
be a false negative (4,13). It has been suggested that: i)
Positive macrophage peroxynitrite-staining in pathologic tissues;
ii) anomalies in pathological specimens and a positive T.
whipplei polymerase chain reaction (PCR); and iii) a positive
T. whipplei PCR in sterile tissues can validate the
diagnosis of WD. When one of the three aforementioned criteria are
met, the diagnosis is verified (14).
mNGS has performed well in identifying rare, novel,
difficult-to-detect and co-infectious pathogens directly from
clinical samples and has shown great potential in resistance
prediction by sequencing antibiotic resistance genes, providing new
diagnostic evidence that can be used to guide the treatment of
infectious diseases (15). Owing
to the rapid development of mNGS, the number of confirmed cases of
WD has increased significantly, and the number of related case
reports has also increased in recent years compared with the
previous ones (16-18).
The three patients with WD reported in the present study had their
pathogens identified by mNGS.
The treatment of WD is mainly antibiotic
anti-infection treatment; commonly used drugs include penicillin,
tetracycline, streptomycin, ceftriaxone, meropenem,
hydroxychloroquine, doxycycline and cotrimoxazole (4). Initial treatment with ceftriaxone and
meropenem for 2 weeks followed by maintenance treatment with
cotrimoxazole for ~1 year is the typical treatment protocol, but in
recent years, some studies have shown that T. whipplei is
resistant to cotrimoxazole, which may increase the chances of
recurrence of WD (19-21).
In this situation, doxycycline combined with hydroxychloroquine as
an alternative treatment can also achieve improved efficacy
(19-21).
In the present case reports, one patient improved
after treatment with ceftriaxone combined with cotrimoxazole; one
patient improved after treatment with meropenem combined with
cotrimoxazole; and one patient benefited after treatment with
ceftriaxone combined with minocycline. There are fewer reports
related to the treatment of WD with minocycline, which provides
some value to the study of minocycline for WD. Clinical symptoms of
WD improve significantly within a few days to weeks after treatment
with antibiotics, but WD requires a certain period of maintenance
therapy to prevent recurrence (22). Nevertheless, WD has a lifelong
potential for relapse, and Lin et al (6) suggested that the disease requires
lifelong monitoring.
WD is a rare multi-system disease with no obvious
specificity in clinical manifestations, laboratory tests, or
imaging tests. Currently, WD can be diagnosed by mNGS detection of
T. whipplei, which can achieve early diagnosis and early
treatment. Previous studies only indicated that WD disease damages
the respiratory system, but there were no concrete case reports. In
the present case report, the three patients, all with the
respiratory system as the main manifestation, achieved good
efficacy after treatment, and there was no recurrence or death in
the follow-up, which provides a valuable reference for the
diagnosis and treatment of WD in the future. Since they did not
have obvious symptoms of other systems, they did not have other
system-related examinations, which demonstrates that clinical
physicians need to fully communicate with the patients and screen
for multisystemic diseases in WD. Furthermore, to the best of our
knowledge, there have been no reports of differences in symptoms or
prognosis due to differences of ethnicity. It is necessary to merge
Asian and Caucasian data on Whipple's disease for analysis to
clarify whether ethnic differences lead to different symptoms or
prognosis; however, due to regional discrepancies, the present
study was unable to do this.
Acknowledgements
Not applicable.
Funding
Funding: No funding was received.
Availability of data and materials
The data generated in the present study may be
requested from the corresponding author.
Authors' contributions
YD conceived and designed the work. YD and XC
analyzed and summarized the data and wrote the manuscript. HZ, ZZ,
JL and TZ collected the laboratory examination and CT images of the
case. XC critically revised the manuscript. YD and XC confirm the
authenticity of all the raw data. All authors read and approved the
final manuscript.
Ethics approval and consent to
participate
This study was conducted in accordance with the
principles expressed in the Declaration of Helsinki and was
approved by the Research Medical Ethics Committee of the Second
Affiliated Hospital of Chongqing Medical University.
Patient consent for publication
The patients involved in the present study were
subjected to standard clinical practice and provided written,
informed consent for publication.
Competing interests
The authors declare that they have no competing
interests.
References
|
1
|
Kutlu O, Erhan SS, Gökden Y, Kandemir Ö
and Tükek T: Whipple's Disease: A case report. Med Princ Pract.
29:90–93. 2020.PubMed/NCBI View Article : Google Scholar
|
|
2
|
Lagier JC, Papazian L, Fenollar F, Edouard
S, Melenotte C, Laroumagne S, Michel G, Martin C, Gainnier M, Lions
C, et al: Tropheryma whipplei DNA in bronchoalveolar lavage
samples: A case control study. Clin Microbiol Infect. 22:875–879.
2016.PubMed/NCBI View Article : Google Scholar
|
|
3
|
El-Abassi R, Soliman MY, Williams F and
England JD: Whipple's disease. J Neurol Sci. 377:197–206.
2017.PubMed/NCBI View Article : Google Scholar
|
|
4
|
Dolmans RA, Boel CH, Lacle MM and Kusters
JG: Clinical manifestations, treatment, and diagnosis of
Tropheryma whipplei infections. Clin Microbiol Rev.
30:529–555. 2017.PubMed/NCBI View Article : Google Scholar
|
|
5
|
Biagi F, Balduzzi D, Delvino P, Schiepatti
A, Klersy C and Corazza GR: Prevalence of Whipple's disease in
north-western Italy. Eur J Clin Microbiol Infect Dis. 34:1347–1348.
2015.PubMed/NCBI View Article : Google Scholar
|
|
6
|
Lin M, Wang K, Qiu L, Liang Y, Tu C, Chen
M, Wang Z, Wu J, Huang Y, Tan C, et al: Tropheryma whipplei
detection by metagenomic next-generation sequencing in
bronchoalveolar lavage fluid: A cross-sectional study. Front Cell
Infect Microbiol. 12(961297)2022.PubMed/NCBI View Article : Google Scholar
|
|
7
|
Ojeda E, Cosme A, Lapaza J, Torrado J,
Arruabarrena I and Alzate L: Whipple's disease in Spain: A clinical
review of 91 patients diagnosed between 1947 and 2001. Rev Esp
Enferm Dig. 102:108–123. 2010.PubMed/NCBI View Article : Google Scholar : (In English,
Spanish).
|
|
8
|
Dutly F and Altwegg M: Whipple's disease
and ‘Tropheryma whippelii’. Clin Microbiol Rev. 14:561–583.
2001.PubMed/NCBI View Article : Google Scholar
|
|
9
|
Freeman HJ: Tropheryma whipplei
infection. World J Gastroenterol. 15:2078–2080. 2009.PubMed/NCBI View Article : Google Scholar
|
|
10
|
Marth T, Moos V, Müller C, Biagi F and
Schneider T: Tropheryma whipplei infection and Whipple's
disease. Lancet Infect Dis. 16:e13–e22. 2016.PubMed/NCBI View Article : Google Scholar
|
|
11
|
Ruggiero E, Zurlo A, Giantin V, Galeazzi
F, Mescoli C, Nante G, Petruzzellis F and Manzato E: Short article:
Relapsing Whipple's disease: A case report and literature review.
Eur J Gastroenterol Hepatol. 28:267–270. 2016.PubMed/NCBI View Article : Google Scholar
|
|
12
|
Obst W, von Arnim U and Malfertheiner P:
Whipple's Disease. Viszeralmedizin. 30:167–172. 2014.PubMed/NCBI View Article : Google Scholar
|
|
13
|
Crews NR, Cawcutt KA, Pritt BS, Patel R
and Virk A: Diagnostic approach for classic compared with localized
whipple disease. Open Forum Infect Dis. 5(ofy136)2018.PubMed/NCBI View Article : Google Scholar
|
|
14
|
Duss FR, Jaton K, Vollenweider P, Troillet
N and Greub G: Whipple disease: A 15-year retrospective study on 36
patients with positive polymerase chain reaction for Tropheryma
whipplei. Clin Microbiol Infect. 27:910.e9–910.e13.
2021.PubMed/NCBI View Article : Google Scholar
|
|
15
|
Han D, Li Z, Li R, Tan P, Zhang R and Li
J: mNGS in clinical microbiology laboratories: On the road to
maturity. Crit Rev Microbiol. 45:668–685. 2019.PubMed/NCBI View Article : Google Scholar
|
|
16
|
Zhang WM and Xu L: Pulmonary parenchymal
involvement caused by Tropheryma whipplei. Open Med (Wars).
16:843–846. 2021.PubMed/NCBI View Article : Google Scholar
|
|
17
|
Chen Q, Niu YL and Zhang T: Diagnosis and
treatment of Whipple disease after kidney transplantation: A case
report. World J Clin Cases. 11:6019–6024. 2023.PubMed/NCBI View Article : Google Scholar
|
|
18
|
Fang Z, Liu Q, Tang W, Yu H, Zou M, Zhang
H, Xue H, Lin S, Pei Y, Ai J and Chen J: Experience in the
diagnosis and treatment of pneumonia caused by infection with
Tropheryma whipplei: A case series. Heliyon.
9(e17132)2023.PubMed/NCBI View Article : Google Scholar
|
|
19
|
Hujoel IA, Johnson DH, Lebwohl B, Leffler
D, Kupfer S, Wu TT, Murray JA and Rubio-Tapia A: Tropheryma
whipplei Infection (Whipple Disease) in the USA. Dig Dis Sci.
64:213–223. 2019.PubMed/NCBI View Article : Google Scholar
|
|
20
|
Camboulive A, Jutant EM, Savale L, Jaïs X,
Sitbon O, Mussini C, Bénichou J, Lagier JC, Humbert M and Montani
D: Reversible pulmonary hypertension associated with multivisceral
Whipple's disease. Eur Respir J. 57(2003132)2021.PubMed/NCBI View Article : Google Scholar
|
|
21
|
Feurle GE, Moos V, Bläker H, Loddenkemper
C, Moter A, Stroux A, Marth T and Schneider T: Intravenous
ceftriaxone, followed by 12 or three months of oral treatment with
trimethoprim-sulfamethoxazole in Whipple's disease. J Infect.
66:263–270. 2013.PubMed/NCBI View Article : Google Scholar
|
|
22
|
Hagel S, Epple HJ, Feurle GE, Kern WV,
Lynen Jansen P, Malfertheiner P, Marth T, Meyer E, Mielke M, Moos
V, et al: S2k-guideline gastrointestinal infectious diseases and
Whipple's disease. Z Gastroenterol. 53:418–459. 2015.PubMed/NCBI View Article : Google Scholar : (In German).
|